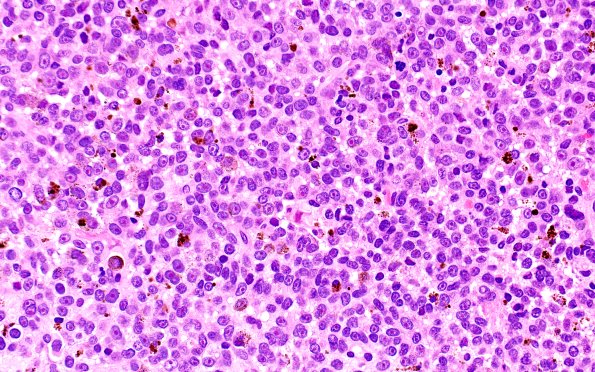
11A2 Melanoma (Case 11) H&E 40X

Table of Contents
Washington University Experience | NEOPLASMS (METASTASES) | Melanoma | 11A2 Melanoma (Case 11) H&E 40X
H&E-stained sections show brain parenchyma infiltrated by a metastatic pigmented neoplasm composed of moderately pleomorphic cells with amphophilic cytoplasm. The tumor cells have atypical nuclei with lightly granular chromatin and 'cherry-red' nucleoli. Mitoses are abundant, and the background tissue shows extensive hemorrhage.